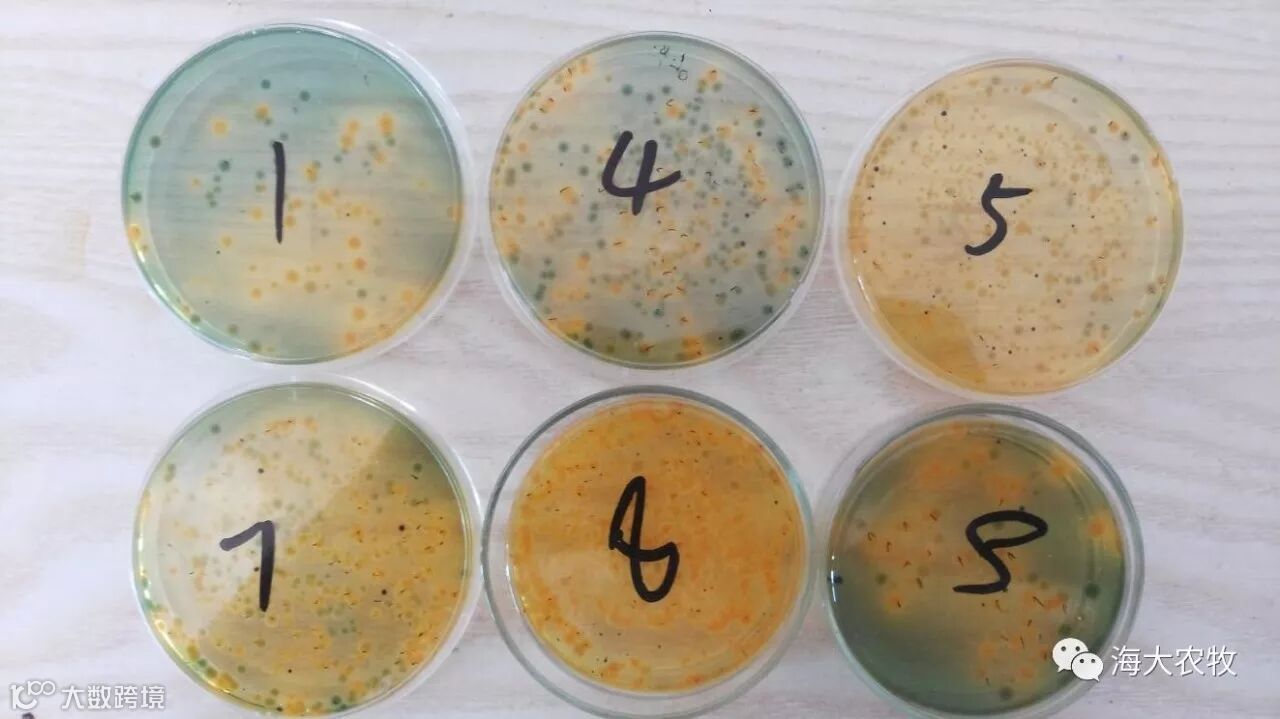

文 | 图 福建海大 李佳凯、王福扬
误区一:不分时节,高温期(水温>30℃)依然选择肥水放苗
▲ 易出现的问题:
A.水质不稳定,易倒藻,弧菌超标;
B.透明度低,悬浮颗粒多;
C.死藻沉积,烂底,底坏;
D.综合导致养殖30-40天发病率高,福清高位池该阶段发病率甚至达9成以上。
▲ 解决思路:
选择清水或爽水放苗
▲ 养户顾虑:
清水透明度过高,虾苗应激大
▲ 解决方案:
进水消毒后,黑精灵遮光、全家桶做水
A.泡菌15斤/亩(2天一次),泡肥5-10斤/亩(3天一次)
B.放苗前一天,黑精灵2斤/亩,进行遮光

误区二:投喂不合理,乱加料,看到别人投的多,自己也要加得快
▲ 易出现问题:
A.肠炎频发,转肝不顺,红肝、黄肝、肝肿大等;
B.料未吃完,底臭、坏底,病菌滋生;
C.投的越多,加的越凶,死的越快
D.一些客户加料过快,从一餐5斤直接加到10斤,基本2-3天就会出现空肠、空胃、肝脏萎缩、偷死等症状,紧接着出现大量损耗。
▲ 解决思路:
根据虾苗的投放密度与规格,进行科学的投喂和加料,养殖中前期可参照下表进行投喂管理:

误区三:怕虾苗跑掉,底网(40-60目)放置时间长达30-40天
▲ 易出现的问题:
排污不畅,排污很臭,底易坏
▲ 解决思路:
缩短底网放置时间,10-15天就可以拔掉,担心跑苗的老板们,可以参考福建长乐高位池老板做的插管查苗装置观察。

排污插管
误区四:养殖前期,觉得苗小投料少,不用改底或改底频率低,10-15天才改底一次
▲ 易出现的问题:
A.因为虾苗小,爬底能力很弱,排污不干净,所以早期的底质更容易脏;
B.小苗吃了很多底部的脏东西,容易出现肠炎、拖便、肝发红现象;
C.水容易浓,虾苗应激大,导致蜕壳不遂,出现白苗损耗。
▲ 解决思路:
加大改底频率,使用活菌和氧化剂改底。
▲ 养户顾虑:
改底产品对虾苗有刺激。建议选择安全高效的底改产品,如海联科靓底、养底力士,改底又抑菌,安全又可靠。
▲ 解决方案:
A.放苗第3天开始改底,后5天改底一次;
B.第一天晚上,靓底+养底力士(各半包/亩);
C.第二天上午,强力倍生源(100克/亩)+益水光合素(半桶/亩)。

水浓、水脏(投苗5天)
误区五:排污次数少,放苗10天,每天排污才2-4次
▲ 易出现的问题:
冬棚养殖前期水温比较高,对虾的消化代谢和藻类的繁衍速度很快,弧菌的滋生速度也很快,没有及时排出去的污渍会变成弧菌生长的培养基,导致虾苗感染发病。
▲ 解决思路:
加大排污次数,尤其是晚上排污次数一定要多,大型养殖场应加强晚上值班。通常放苗10天,排污要达到7次以上。如下图所示,长乐蔡老板,养殖中后期(夏季高温)一天排污次数达12次,每2小时排污(拔臭)一次。

误区六:换水少,高温天放苗10天时,较多客户换水才5公分
▲ 解决思路:
养殖前期水温高于28℃时,可以适当加大换水量,更有利于保持水质清爽和稳定。一般放苗10天,换水量要达到10-15公分。
▲ 养户顾虑:
换水量大,对虾苗应激大,而且还浪费泼洒的药品。
▲ 解决方案:
泼洒到水里的药品,一般作用时间是很快的,不会在水体里面长时间停留,所以排污对药效的影响很小。换水量大时,可以使用钙速补(半瓶/亩)+泼水高稳C(1包/亩)补钙抗应激,一般三天用一次即可。
误区七:水位高,最浅1.1-1.2米,最深1.8-2.0米,平均水位在1.4-1.5米
▲ 易出现的问题:
A.水位太高,换水的效率变低。例如,同样是换水20公分,1.5米水位的换水量仅为13.3%,1.2米水位的换水量为16.6%,而1米水位的换水量可以达到20%;
B.水位高,增氧机打不到底,不利于集污,导致底坏;
C.水位高,用药的有效浓度降低,用药的成本增加;
D.水位高,底部溶氧低,细菌易滋生,底部环境差。
▲ 养户顾虑:
水位低,水温会高,虾苗会被晒死。而笔者实际测量的情况看,水位在1米与1.5米,下层水温差距仅在0.3-0.5度,影响不大。
▲ 解决思路:
适当降低水位,养殖中前期平均水位保持在0.9-1.1米即可。
误区八:水源未处理,高温天,海水水源较差,弧菌超标、荧光藻较多,未有地下水源
▲ 易出现的问题:
水源带来大量弧菌,使池塘弧菌严重超标。
▲ 解决思路:
养殖场要设置蓄水池,水先进到蓄水池进行消毒处理,再加到养殖塘(蓄水池的设置和使用,可参照《养殖密集区域有蓄水池,成功率将远高于其他养殖户》点击即可查看)。
▲ 解决方案:
水源进到蓄水池后,使用水卫士2包/亩+强氯精30斤/亩(30%有效含量)进行立体杀藻消毒,第三天可加到养殖塘中使用。每次进水消毒后,建议三天内用完。
夏季海水水源弧菌
高位池养殖30-40天发病率高已经成为通病,给广大养殖户造成严重损失,强烈打击养殖的信心。所谓细节决定成败,根据笔者的塘头服务观察,日常生产管理不到位是问题的主因,特列举常见的八大误区及解决方案,祝各位老板2017年冬棚养殖顺利!
请输入标题 bcdef
【养虾王道】
科学养大虾,高手同交流,效益真正有

请输入标题 abcdefg



